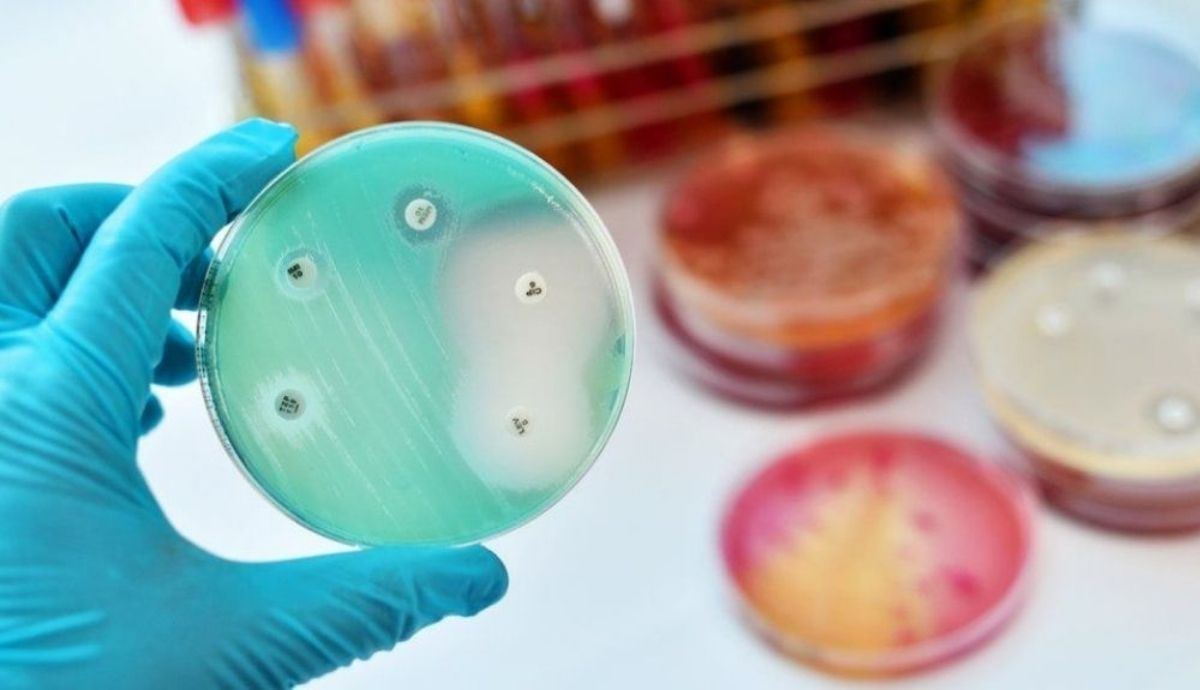

El estudio sobre el uso de los medicamentos señala que los países más pobres son los más afectados, pero la resistencia a los antimicrobianos amenaza la salud de todos. De tal forma que se recomienda la inversión urgente en nuevos medicamentos y el uso más sabio de los actuales para protegerse contra ellos.
Las personas están muriendo de infecciones comunes, previamente tratables, porque las bacterias que las causan se han vuelto resistentes al tratamiento
El uso excesivo de antibióticos en los últimos años para infecciones triviales significa que se están volviendo menos efectivos contra infecciones graves. Así, las personas están muriendo de infecciones comunes, previamente tratables, porque las bacterias que las causan se han vuelto resistentes al tratamiento.
En este sentido, funcionarios de salud del Reino Unido advirtieron recientemente que la resistencia a los antimicrobianos (RAM) era una "pandemia oculta" que podría resurgir a raíz de la Covid-19, a menos que los antibióticos se prescribieran de manera responsable.
Particularmente mortal
La estimación de las muertes globales por RAM, publicada en The Lancet, se basa en un análisis de 204 países realizado por un equipo de investigadores internacionales, dirigido por la Universidad de Washington, Estados Unidos.

Calculan que hasta cinco millones de personas murieron en 2019 por enfermedades en las que la RAM jugó un papel, además de los 1,2 millones de muertes que causó directamente.
La mayoría de las muertes por RAM fueron causadas por infecciones de las vías respiratorias inferiores, como la neumonía, e infecciones del torrente sanguíneo, que pueden conducir a la sepsis
En el mismo año, se cree que el SIDA (Síndrome de Inmunodeficiencia Adquirida) causó 860.000 muertes y la malaria 640.000.
La mayoría de las muertes por RAM fueron causadas por infecciones de las vías respiratorias inferiores, como la neumonía, e infecciones del torrente sanguíneo, que pueden conducir a la sepsis. MrsA (Staphylococcus aureusresistente a la meticilina) fue particularmente mortal, mientras que E. coli, y varias otras bacterias, también se relacionaron con altos niveles de resistencia a los medicamentos.
Datos sobre las muertes por la resistencia a los antimicrobianos
Por otro lado, utilizando registros de pacientes de hospitales, estudios y otras fuentes de datos, los investigadores dicen que los niños pequeños están en mayor riesgo, con aproximadamente una de cada cinco muertes relacionadas con la RAM, entre los menores de cinco años.
Asimismo, se señala que las muertes por RAM fueron más altas en África subsahariana y Asia meridional, con 24 muertes por cada 100.000 y más bajas en los países de altos ingresos, con 13 por cada 100.000.

Al respecto, el profesor Chris Murray, del Instituto de Métricas y Evaluación de la Salud de la Universidad de Washington, advirtió que los nuevos datos revelaron la verdadera escala de la resistencia a los antimicrobianos en todo el mundo y fueron una clara señal de que se necesitaba una acción inmediata "si queremos mantenernos a la vanguardia en la carrera contra la resistencia a los antimicrobianos”.
"El gasto debe dirigirse a prevenir infecciones en primer lugar, asegurarse de que los antibióticos existentes se usen de manera adecuada y juiciosa, y a llevar nuevos antibióticos al mercado"
Otros expertos señalan que es esencial un mejor seguimiento de los niveles de resistencia en diferentes países y regiones. El doctor Ramanan Laxminarayan, del Centro de Dinámica de Enfermedades, Economía y Política, en Washington DC, apuntó que el gasto mundial en abordar la RAM necesitaba aumentar a los niveles observados para otras enfermedades.
"El gasto debe dirigirse a prevenir infecciones en primer lugar, asegurarse de que los antibióticos existentes se usen de manera adecuada y juiciosa, y a llevar nuevos antibióticos al mercado", declaró.
“Gran parte del mundo se enfrenta al desafío del acceso deficiente a antibióticos asequibles y efectivos, y eso debe ser tomado en serio por los líderes políticos y de salud de todo el mundo”, concluyó Laxminarayan.
Fuente: BBC.